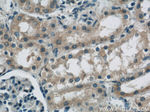
FRK Antibody in Immunohistochemistry (Paraffin) (IHC (P))

Search
Proteintech
FRK Polyclonal Antibody
{{$productOrderCtrl.translations['antibody.pdp.commerceCard.promotion.promotions']}}
{{$productOrderCtrl.translations['antibody.pdp.commerceCard.promotion.viewpromo']}}
{{$productOrderCtrl.translations['antibody.pdp.commerceCard.promotion.promocode']}}: {{promo.promoCode}} {{promo.promoTitle}} {{promo.promoDescription}}. {{$productOrderCtrl.translations['antibody.pdp.commerceCard.promotion.learnmore']}}
产品信息
16197-1-AP
种属反应
宿主/亚型
分类
类型
抗原
偶联物
形式
浓度
规格
纯化类型
保存液
内含物
保存条件
运输条件
产品详细信息
Immunogen sequence: QLLKRLGSG QFGEVWEGLW NNTTPVAVKT LKPGSMDPND FLREAQIMKN LRHPKLIQLY AVCTLEDPIY IITELMRHGS LQEYLQNDTG SKIHLTQQVD MAAQVASGMA YLESRNYIHR DLAARNVLVG EHNIYKVADF GLARVFKVDN EDIYESRHEI KLPVKWTAPE AIRSNKFSIK SDVWSFGILL YEIITYGKMP YSGMTGAQVI QMLAQNYRLP QPSNCPQQFY NIMLECWNAE PKERPTFETL RWKLEDYFET DSSYSDANNF IR (235-505 aa encoded by BC012916)
靶标信息
FRK (PTK5) is a nuclear protein and may function during G1 and S phase of the cell cycle, suppressing growth. The human FRK gene maps to chromosome 6q21-q22.3 and encodes a 505 amino acid protein. The protein belongs to the TYR family of protein kinases. This tyrosine kinase is a nuclear protein and may function during G1 and S phase of the cell cycle and suppress growth.
仅用于科研。不用于诊断过程。未经明确授权不得转售。
篇参考文献 (0)
生物信息学
蛋白别名: B-cell src-homology tyrosine kinase; Beta-cell Src-homology tyrosine kinase; BSK; EC 2.7.1.112; EC 2.7.10.2; FYN-related kinase; GASK; Gastrointestinal-associated kinase; Gastrointestinal-associated tyrosine kinase; GTK; Intestine tyrosine kinase; Nuclear tyrosine protein kinase RAK; Protein-tyrosine kinase 5; PTK5 protein tyrosine kinase 5; src related tyrosine kinase; Tyrosine-protein kinase FRK; unnamed protein product
基因别名: BSK; BSK/IYK; C85044; FRK; Gask; GTK; Iyk; PTK5; RAK
UniProt ID: (Human) P42685, (Mouse) Q922K9, (Rat) Q62662
Entrez Gene ID: (Human) 2444, (Mouse) 14302, (Rat) 79209